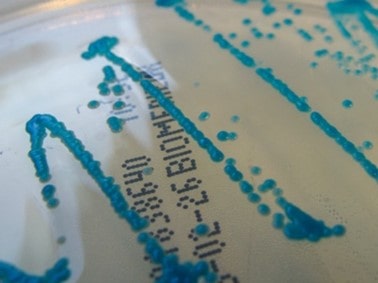
Cultivo de C. dubliniensis de Nathan Reading

Candida dubliniensis es un hongo dimórfico, perteneciente al filo Ascomycota. Dentro del género Candida, es la especie que está más estrechamente relacionada filogenéticamente con C. albicans, con gran similitud en las características fenotípicas de ambas especies, como es la capacidad de producir clamidosporas y la formación de un tubo germinal (16). Sus diferencias radican en ciertas características epidemiológicas, virulencia y capacidad de desarrollar resistencia a determinados medicamentos (3) (6) (7).
En forma de levadura presenta un aspecto de células ovoides o esféricas, mientras que, como hongo filamentoso, forma pseudohifas e incluso hifas verdaderas con septos definidos que dividen las hifas en unidades fúngicas separadas (artroconidias). A diferencia de C. albicans, la producción de clamidosporas es, generalmente, más abundante y presentan una distribución inusual en pequeños grupos (14) (15) (17).
Macroscópicamente, en agar Sabouraud crece formando colonias de color blanco o crema y consistencia blanda. En medios de cultivo cromogénicos, las colonias presentan un tono verde oscuro (3) (7) (9) (15).
Viabilidad, propagación y transmisión
Reservorio
Humano (cavidad oral, microflora de la piel y tracto genitourinario). El excremento de aves marinas ha sido identificado como una posible fuente de C. dubliniensis y, por tanto, se relaciona con que pueda habitar en el tracto digestivo de estas aves (7) (11).
Hospedadores
Humanos. Estudios recientes que han aislado C. dubliniensis de fuentes ambientales indican que posiblemente esta especie no esté limitada a los humanos (7) (10) (11).
Dosis Infectiva Mínima (DIM)
Se desconoce en la actualidad.
Supervivencia ambiental
C. dubliniensis es susceptible a las condiciones de estrés ambiental, como son las altas temperaturas, la presión osmótica y el estrés oxidativo. De hecho, se ha observado que su tasa de crecimiento es menor, en comparación con otras especies de Candida, como C. albicans; y no es capaz de crecer a partir de 42 ˚C-45 ˚C (3) (9) (16).
Formas de resistencia
Las clamidosporas son un tipo de esporas resistentes formadas por reproducción asexual bajo determinadas condiciones, como es la escasez de nutrientes. Son estructuras característicamente grandes, de 6-12 µm de diámetro, con forma redonda u oval y pared celular gruesa y refringente. Sin embargo, es poco probable que las clamidosporas formadas por C. dubliniensis y C. albicans actúen como formas de resistencia a largo plazo, ya que se ha analizado su susceptibilidad a diferentes factores de estrés ambiental in vitro y se ha demostrado que su tolerancia ambiental es similar a la de la levadura (4) (9).
Mecanismo de propagación y transmisión
Esta especie de Candida se encuentra en la flora microbiana normal de las personas, mayoritariamente en la cavidad oral. Se cree que las infecciones producidas por este hongo tienen principalmente origen endógeno, actuando como un microorganismo oportunista. La transmisión exógena puede producirse por contacto con personas infectadas, principalmente a través de las mucosas, y materiales contaminados.
Afecta sobre todo a individuos con un sistema inmune debilitado, que han estado sometidos a medicación, que padecen diabetes o que utilizan prótesis dentales removibles (1) (3) (16).
Vías de entrada
Dérmica. Mucosas.
Distribución geográfica
Mundial.
Efectos sobre la salud
Grupo de riesgo
2
(Ver Anexo II RD 664/1997 )Infección
Es frecuente que C. dubliniensis sea el agente causante de candidiasis orales, concretamente, candidiasis eritematosa y candidiasis pseudomembranosa; afectando sobre todo a individuos infectados por el virus de la inmunodeficiencia humana (VIH) y pacientes con SIDA (13) (15). También se observa una mayor tasa de prevalencia de este patógeno en pacientes que padecen diabetes, fibrosis quística o cáncer (7) (10) (12) (16).
La candidiasis eritematosa se manifiesta en la mucosa oral como una zona enrojecida con bordes poco definidos, sin la presencia de placas blanquecinas. Por lo general, esta lesión es asintomática, aunque ocasionalmente puede causar un leve picor (1).
En el caso de la candidiasis pseudomembranosa, esta se caracteriza por la presencia de placas blanquecinas o amarillentas de consistencia blanda que se desarrollan en la mucosa oral. Pueden ser fácilmente raspadas, dejando una zona eritematosa o ulcerada. Estas lesiones se encuentran más comúnmente en la mucosa yugal, orofaringe y bordes laterales de la lengua. En la mayoría de los casos, los síntomas son leves, pero en ocasiones los pacientes pueden experimentar dolor, ardor o disfagia (1).
También ha sido aislada de otras partes del cuerpo, por tanto, en ocasiones puede producir otras afecciones clínicas como candidiasis superficial, estomatitis crónica, candidiasis mucocutánea, vulvovaginitis y, puede derivar en cuadros más graves (3) (9). No obstante, los estudios epidemiológicos revelan que rara vez se asocia con infecciones sistémicas, siendo responsable de un bajo porcentaje de los casos de candidemia. Esto sugiere que C. dubliniensis es menos patógena que otras especies pertenecientes al género, como C. albicans (5) (16).
Efectos alérgicos (Ver Anexo II RD 664/1997 ) / (Ver Allergen )
No se han descrito.
Efectos tóxicos (Ver Anexo II RD 664/1997 )
No se han descrito.
Efectos cancerígenos (Ver International Agency for Research On Cancer - IARC )
No se han descrito.
Efectos en la maternidad
No hay información relativa a los efectos en la maternidad para esta especie concreta. Sin embargo, se han documentado casos de infección por Candida del recién nacido a partir de candidiasis vaginal materna o a través del personal sanitario (1).
Enfermedad
| CIE-10 | Nombre | Enfermedad de Declaración Obligatoria |
|---|---|---|
| B37 | Candidiasis | No |
Actividades laborales con riesgo
Clasificación Nacional de Actividades Económicas (CNAE)
| CNAE 2009 | Descripción |
|---|---|
| E3700 | Recogida y tratamiento de aguas residuales |
| E3811 | Recogida de residuos no peligrosos |
| E3900 | Actividades de descontaminación y otros servicios de gestión de residuos |
| N7210 | Investigación y desarrollo experimental en ciencias naturales y técnicas |
| O8123 | Otras actividades de limpieza |
| R8610 | Actividades hospitalarias |
| R8621 | Actividades de medicina general y de medicina familiar y comunitaria |
| R8623 | Actividades odontológicas |
| R8699 | Otras actividades sanitarias n.c.o.p. |
| R8710 | Asistencia en establecimientos residenciales con cuidados sanitarios |
Clasificación Nacional de Ocupaciones (CNO)
| CNO 2011 | Descripción |
|---|---|
| 2111 | Médicos de familia |
| 2112 | Otros médicos especialistas |
| 2121 | Enfermeros no especializados |
| 2122 | Enfermeros especializados (excepto matronos) |
| 2151 | Odontólogos y estomatólogos |
| 3132 | Técnicos en instalaciones de tratamiento de residuos, de aguas y otros operadores en plantas similares |
| 3313 | Técnicos en anatomía patológica y citología |
| 3314 | Técnicos en laboratorio de diagnóstico clínico |
| 3316 | Técnicos en prótesis dentales |
| 3321 | Técnicos superiores en higiene bucodental |
| 5611 | Auxiliares de enfermería hospitalaria |
| 5612 | Auxiliares de enfermería de atención primaria |
| 5622 | Técnicos de emergencias sanitarias |
| 5629 | Trabajadores de los cuidados a las personas en servicios de salud no clasificados bajo otros epígrafes |
| 5710 | Trabajadores de los cuidados personales a domicilio |
| 9229 | Otro personal de limpieza |
| 9441 | Recogedores de residuos |
Prevención y control
Desinfectantes
No hay datos para C. dubliniensis, pero son desinfectantes eficaces contra los microorganismos del género Candida el hipoclorito sódico > 0,39 % durante un minuto; hipoclorito sódico al 0,825 % (dilución 1:10) durante un minuto; ácido peracético 1200 ppm, peróxido de hidrógeno < 1 % y ácido acético durante tres minutos; peróxido de hidrógeno al 1,4 % durante tres minutos y al 0,5 % durante diez minutos (2).
Inactivación física
No hay información para C. dubliniensis, pero la mayoría de las especies del género Candida se inactivan con vapor saturado a 121 °C durante al menos 15 minutos. La radiación ultravioleta puede contribuir a la eliminación de biopelículas de Candida (8).
Antimicrobianos
Es sensible a los medicamentos antimicóticos de uso común como la anfotericina B, las equinocandinas y los azoles (fluconazol, itraconazol o ketoconazol). Sin embargo, se han encontrado algunas cepas de C. dubliniensis que son resistentes al fluconazol y, además, se ha observado la capacidad de desarrollar una respuesta rápida de resistencia a este fármaco in vitro (3) (5) (13) (15).
Vacunación
No disponible.
Medidas preventivas generales
Evitar el exceso de humedad y de temperatura en los locales de trabajo.
Orden y limpieza en el lugar de trabajo, limpieza y desinfección de instalaciones, equipos y herramientas.
Guardar la comida en lugares y condiciones adecuadas (refrigeración), no comer en el lugar de trabajo, ni con la ropa o manos sucias.
Higiene personal, mantener la piel limpia y seca, especialmente en las zonas de los pliegues, lavado de manos después de tocar materiales o elementos potencialmente contaminados. Utilizar ropa de trabajo que permita la transpiración y evite la sudoración excesiva. Cambiarse la ropa o el calzado mojado o húmedo.
No compartir objetos personales.
Precauciones en centros sanitarios
En hospitales o centros sanitarios, adoptar las Precauciones Estándar (20).
EPI
Protección de las manos: guantes de protección frente a microorganismos para manipular sustancias, pacientes o equipos que pueden estar contaminados (véase la NTP 1143) (19).
Protección ocular: gafas de protección de montura universal en caso de riesgo de contacto accidental mano/guante contaminado-ojo, o pantalla de protección facial en caso de riesgo de exposición por salpicaduras (símbolo de marcado en montura: 3).
Seguridad en laboratorio
Nivel de contención: 2
Los principales riesgos son la exposición de las mucosas a gotas o aerosoles, el contacto con fluidos y tejidos infecciosos, la inoculación y la ingesta accidental.
Las muestras más peligrosas son especímenes biológicos como el esputo, lavados bronquiales, heces, orina, tejidos (piel o mucosa), exudados de heridas, líquido cefalorraquídeo y sangre.
Se requieren las prácticas y la contención de un nivel 2 de bioseguridad. Limitar el número de trabajadores que tienen acceso al laboratorio y velar por el cumplimiento de las medidas higiénicas. Aplicación de procedimientos adecuados de limpieza y desinfección. Limitar el empleo de material cortante o punzante. Utilizar cabina de seguridad biológica en aquellas operaciones que impliquen la generación de aerosoles, proyecciones o salpicaduras. Uso de ropa de trabajo. Utilizar guantes de protección frente a microorganismos en el caso de contacto con muestras contaminadas.
Bibliografía
- Aguirre, J. M. (2002). Candidiasis orales. Revista iberoamericana de micología, 19, 17-21.
- Cadnum, J. L., Shaikh, A. A., Piedrahita, C. T., Sankar, T., Jencson, A. L., Larkin, E. L., Ghannoum, M. A., & Donskey, C. J. (2017). Effectiveness of disinfectants against Candida auris and other Candida species. Infection control and hospital epidemiology, 38(10), 1240–1243. DOI: 10.1017/ice.2017.162.
- Castro, C., & Martín, E. (2004). Diagnóstico de la infección fúngica por levaduras del género Candida: Candida dubliniensis. Sociedad Española de Enfermedades Infecciosas (SEIMC).
- Citiulo, F., Moran, G. P., Coleman, D. C., & Sullivan, D. J. (2009). Purification and germination of Candida albicans and Candida dubliniensis chlamydospores cultured in liquid media. FEMS yeast research, 9(7), 1051–1060. DOI: 10.1111/j.1567-1364.2009.00533.x.
- Coleman, D. C., Moran, G. P., McManus, B. A., Sullivan, D. J. (2010). Mechanisms of antifungal drug resistance in Candida dubliniensis. Future microbiology, 5(6), 935-949. DOI: 10.2217/fmb.10.51.
- Gutiérrez, J., Morales, P., González, M. A., & Quindós, G. (2002). Candida dubliniensis, a new fungal pathogen. Journal of basic microbiology, 42(3), 207-227. DOI: 10.1002/1521-4028(200206)42:3<207::AID-JOBM207>3.0.CO;2-C.
- Khlif, M., Sellami, A., Sellami, H., Makni, F., & Ayadi, A. (2011). Candida dubliniensis: méthodes d’identification et implications épidémiologiques. Pathologie biologie, 59(3), 166-172. DOI: 10.1016/j.patbio.2008.09.011.
- Li, J., Hirota, K., Yumoto, H., Matsuo, T., Miyake, Y., & Ichikawa, T. (2010). Enhanced germicidal effects of pulsed UV-LED irradiation on biofilms. Journal of applied microbiology, 109(6): 2183-2190. DOI: 10.1111/j.1365-2672.2010.04850.x.
- Linares, M. J., & Solís, F. (2007). Identificación de levaduras. En Guía práctica de identificación y diagnóstico en micología clínica (2ª ed.) (Capítulo 11). Revista Iberoamericana de Micología.
- Loreto, E. S., Scheid, L. A., Nogueira, C. W., Zeni, G., Santurio, J. M., & Alves, S. H. (2010). Candida dubliniensis: epidemiology and phenotypic methods for identification. Mycopathologia, 169, 431-443. DOI: 10.1007/s11046-010-9286-5.
- Nunn, M. A., Schäfer, S. M., Petrou, M. A., & Brown, J. R. (2007). Environmental source of Candida dubliniensis. Emerging infectious diseases, 13(5), 747. DOI: 10.3201/eid1305.061179.
- Paugam, A., Baixench, M. T., & Viguie, C. (2008). Actualités sur Candida dubliniensis. Médecine et maladies infectieuses, 38(1), 1-7. DOI: 10.1016/j.medmal.2007.10.008.
- Schorling, S. R., Kortinga, H. C., Froschb, M., & Mühlschlegel. (2000). The role of Candida dubliniensis in oral candidiasis in human inmunodeficiency virus-infected individuals. Critical reviews in microbiology, 26(1), 59-68. DOI: 10.1080/10408410091154183.
- Silva, S., Negri, M., Henriques, M., Oliveira, R., Williams, D. W., Azeredo, J. (2012). Candida glabrata, Candida parapsilosis and Candida tropicalis: biology, epidemiology, pathogenicity and antifungal resistance. FEMS Microbiology reviews, 36(2), 288-305. DOI: 10.1111/j.1574-6976.2011.00278.x.
- Sullivan, D. J., & Coleman, D. C. (1998). Candida dubliniensis: characteristics and identification. Journal of clinical microbiology, 36(2), 329-334. DOI: 10.1128/jcm.36.2.329-334.1998.
- Sullivan, D. J., Moran, G. P., Pinjon, E., Al-Mosaid, A., Stokes, C., Vaughan, C., & Coleman, D. C. (2004). Comparison of the epidemiology, drug resistance mechanisms, and virulence of Candida dubliniensis and Candida albicans. FEMS Yeast Research, 4(4-5), 369-376. DOI: 10.1016/S1567-1356(03)00240-X.
- Sullivan, D. J., Westerneng, T. J., Haynes, K. A., Bennett, D. E., & Coleman, D. C. (1995). Candida dubliniensis sp. nov.: phenotypic and molecular characterization of a novel species associated with oral candidosis in HIV-infected individuals. Microbiology, 141(7), 1507-1521. DOI: 10.1099/13500872-141-7-1507.
- Institut National de Recherche et de Sécurité (INRS). (2023). Candida dubliniensis. BAse d'OBservation des Agents Biologiques (BAOBAB).
- Instituto Nacional de Seguridad y Salud en el Trabajo (INSST). (2020). Nota Técnica de Prevención (NTP) 1143: Guantes de protección contra microorganismos.
- Servicio Riojano de Salud. (2008). Precauciones de aislamiento en centros sanitarios.